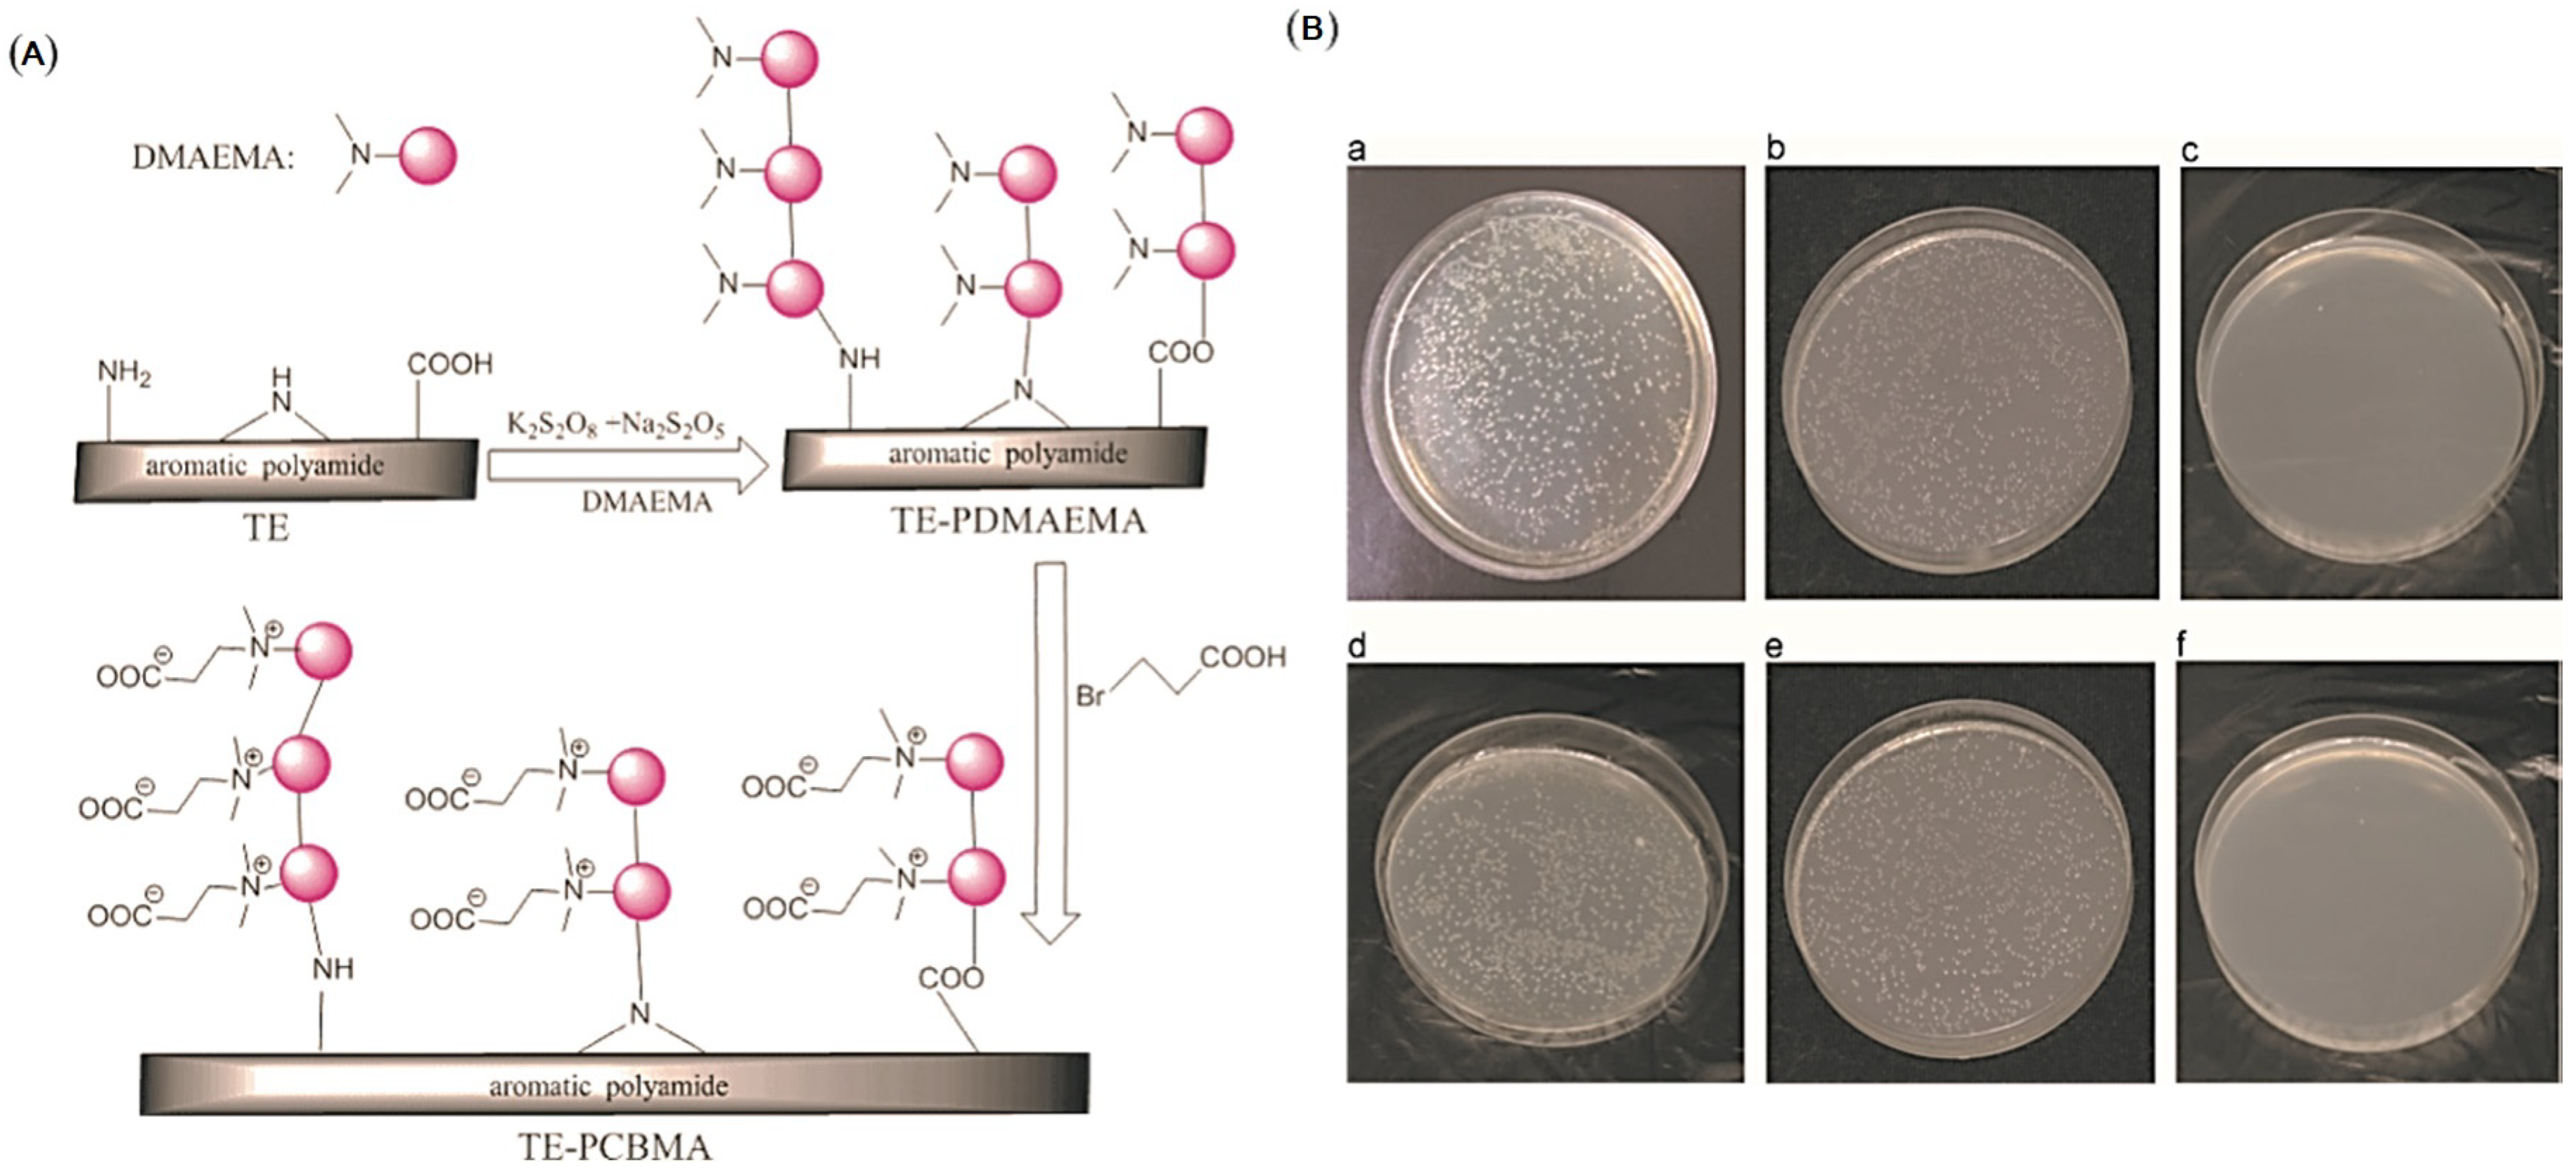
Polymers 14 01167 g003 550

Advancing Strategies of Biofouling Control in Water-Treated Polymeric Membranes
Abstract
:1. Introduction
2. Formation of Membrane Biofouling
3. Influencing Factors of Membrane Biofouling
3.1. The Effect of Microbial Characteristics and Membrane–Microbe Interactions
3.2. The Effect of Membrane Surface Properties
3.3. The Effect of Operating Conditions and Feed Characteristics
4. Prevention and Control of Membrane Biofouling
4.1. Anti-Adhesion Approaches
4.1.1. Hydrophilic Polymers
4.1.2. Zwitterionic/Amphiphilic Polymers
4.1.3. Nanomaterials
4.2. Antimicrobial Approaches
4.2.1. Incorporation of Antimicrobial Nanoparticles (NPs)
4.2.2. Quaternary Ammonium Compounds (QACs)
4.2.3. Guanidine Derivatives
4.3. Integrated Anti-Biofouling Strategies and Others
5. Summary and Outlooks
Author Contributions
Funding
Institutional Review Board Statement
Informed Consent Statement
Data Availability Statement
Acknowledgments
Conflicts of Interest
References
- Culp, T.E.; Khara, B.; Brickey, K.P.; Geitner, M.; Zimudzi, T.J.; Wilbur, J.D.; Jons, S.D.; Roy, A.; Paul, M.; Ganapathysubramanian, B.; et al. Nanoscale control of internal inhomogeneity enhances water transport in desalination membranes. Science 2021, 371, 72–75. [Google Scholar] [CrossRef] [PubMed]
- Eliasson, J. The rising pressure of global water shortages. Nat. Cell Biol. 2014, 517, 6–7. [Google Scholar] [CrossRef] [PubMed]
- Fane, A.G.; Wang, R.; Hu, X. Synthetic Membranes for Water Purification: Status and Future. Angew. Chem. Int. Ed. 2015, 54, 3368–3386. [Google Scholar] [CrossRef] [PubMed]
- Chowdhury, M.R.; Steffes, J.; Huey, B.D.; McCutcheon, J.R. 3D printed polyamide membranes for desalination. Science 2018, 361, 682–686. [Google Scholar] [CrossRef] [PubMed] [Green Version]
- Zhang, H.; Zhu, S.; Yang, J.; Ma, A.; Chen, W. Enhanced removal efficiency of heavy metal ions by assembling phytic acid on polyamide nanofiltration membrane. J. Membr. Sci. 2021, 636, 119591. [Google Scholar] [CrossRef]
- Verbeke, R.; Gómez, V.; Vankelecom, I.F. Chlorine-resistance of reverse osmosis (RO) polyamide membranes. Prog. Polym. Sci. 2017, 72, 1–15. [Google Scholar] [CrossRef]
- Liu, C.; Wang, C.; Guo, Y.; Zhang, J.; Cao, Y.; Liu, H.; Hu, Z.; Zhang, C. High-performance polyamide membrane with tailored water channel prepared via bionic neural networks for textile wastewater treatment. J. Mater. Chem. A 2019, 7, 6695–6707. [Google Scholar] [CrossRef]
- Zuo, K.; Wang, W.; Deshmukh, A.; Jia, S.; Guo, H.; Xin, R.; Elimelech, M.; Ajayan, P.M.; Lou, J.; Li, Q. Multifunctional nanocoated membranes for high-rate electrothermal desalination of hypersaline waters. Nat. Nanotechnol. 2020, 15, 1025–1032. [Google Scholar] [CrossRef] [PubMed]
- Khayet, M. Fouling and Scaling in Desalination. Desalination 2016, 393, 1. [Google Scholar] [CrossRef]
- Chen, Y.; Liang, W.; Li, Y.; Wu, Y.; Chen, Y.; Xiao, W.; Zhao, L.; Zhang, J.; Li, H. Modification, application and reaction mechanisms of nano-sized iron sulfide particles for pollutant removal from soil and water: A review. Chem. Eng. J. 2019, 362, 144–159. [Google Scholar] [CrossRef]
- Tong, X.; Wu, Y.-H.; Wang, Y.-H.; Bai, Y.; Zhao, X.-H.; Luo, L.-W.; Mao, Y.; Ikuno, N.; Hu, H.-Y. Simulating and predicting the flux change of reverse osmosis membranes over time during wastewater reclamation caused by organic fouling. Environ. Int. 2020, 140, 105744. [Google Scholar] [CrossRef]
- Choudhury, R.R.; Gohil, J.M.; Mohanty, S.; Nayak, S.K. Antifouling, fouling release and antimicrobial materials for surface modification of reverse osmosis and nanofiltration membranes. J. Mater. Chem. A 2018, 6, 313–333. [Google Scholar] [CrossRef]
- Liu, C.; Wang, W.; Yang, B.; Xiao, K.; Zhao, H. Separation, anti-fouling, and chlorine resistance of the polyamide reverse osmosis membrane: From mechanisms to mitigation strategies. Water Res. 2021, 195, 116976. [Google Scholar] [CrossRef]
- Wang, Y.-H.; Wu, Y.-H.; Yu, T.; Zhao, X.-H.; Tong, X.; Bai, Y.; Huo, Z.-Y.; Hu, H.-Y. Effects of chlorine disinfection on the membrane fouling potential of bacterial strains isolated from fouled reverse osmosis membranes. Sci. Total Environ. 2019, 693, 133579. [Google Scholar] [CrossRef]
- Guo, Y.; Liu, C.; Liu, H.; Zhang, J.; Li, H.; Zhang, C. Contemporary antibiofouling modifications of reverse osmosis membranes: State-of-the-art insights on mechanisms and strategies. Chem. Eng. J. 2021, 429, 132400. [Google Scholar] [CrossRef]
- Anis, S.F.; Hashaikeh, R.; Hilal, N. Reverse osmosis pretreatment technologies and future trends: A comprehensive review. Desalination 2019, 452, 159–195. [Google Scholar] [CrossRef] [Green Version]
- Goh, P.; Lau, W.; Othman, M.; Ismail, A.F. Membrane fouling in desalination and its mitigation strategies. Desalination 2018, 425, 130–155. [Google Scholar] [CrossRef]
- Kim, J.; Shin, M.; Song, W.; Park, S.; Ryu, J.; Jung, J.; Choi, S.; Yu, Y.; Kweon, J.; Lee, J.-H. Application of quorum sensing inhibitors for improving anti-biofouling of polyamide reverse osmosis membranes: Direct injection versus surface modification. Sep. Purif. Technol. 2021, 255, 117736. [Google Scholar] [CrossRef]
- Yin, Z.; Wen, T.; Li, Y.; Li, A.; Long, C. Pre-ozonation for the mitigation of reverse osmosis (RO) membrane fouling by biopolymer: The roles of Ca2+ and Mg2+. Water Res. 2020, 171, 115437. [Google Scholar] [CrossRef]
- Rho, H.; Cho, J.; Westerhoff, P.; Chon, K. Intrinsic pKa of nanofiltration membrane surfaces to assess fouling and cleaning behaviors induced by foulant-membrane electrostatic interactions. Environ. Sci. Technol. 2020, 54, 7706–7714. [Google Scholar] [CrossRef]
- De Vries, H.J.; Stams, A.J.M.; Plugge, C.M. Biodiversity and ecology of microorganisms in high pressure membrane filtration systems. Water Res. 2020, 172, 115511. [Google Scholar] [CrossRef]
- Wu, J.; Zhang, C.; Xu, S.; Pang, X.; Cai, G.; Wang, J. Preparation of Zwitterionic Polymer-Functionalized Cotton Fabrics and the Performance of Anti-Biofouling and Long-Term Biofilm Resistance. Colloids Interface Sci. Commun. 2018, 24, 98–104. [Google Scholar] [CrossRef]
- Chamani, H.; Woloszyn, J.; Matsuura, T.; Rana, D.; Lan, C.Q. Pore wetting in membrane distillation: A comprehensive review. Prog. Mater. Sci. 2021, 122, 100843. [Google Scholar] [CrossRef]
- Afsari, M.; Shon, H.K.; Tijing, L.D. Janus membranes for membrane distillation: Recent advances and challenges. Adv. Colloid Interface Sci. 2021, 289, 102362. [Google Scholar] [CrossRef] [PubMed]
- Carniello, V.; Peterson, B.W.; van der Mei, H.C.; Busscher, H.J. Physico-chemistry from initial bacterial adhesion to surface-programmed biofilm growth. Adv. Colloid Interface Sci. 2018, 261, 1–14. [Google Scholar] [CrossRef] [PubMed]
- Sánchez, O. Microbial diversity in biofilms from reverse osmosis membranes: A short review. J. Membr. Sci. 2018, 545, 240–249. [Google Scholar] [CrossRef]
- Wang, X.; Zhao, Y.; Yuan, B.; Wang, Z.; Li, X.; Ren, Y. Comparison of biofouling mechanisms between cellulose triacetate (CTA) and thin-film composite (TFC) polyamide forward osmosis membranes in osmotic membrane bioreactors. Bioresour. Technol. 2016, 202, 50–58. [Google Scholar] [CrossRef] [PubMed]
- Zhao, D.L.; Japip, S.; Zhang, Y.; Weber, M.; Maletzko, C.; Chung, T.-S. Emerging thin-film nanocomposite (TFN) membranes for reverse osmosis: A review. Water Res. 2020, 173, 115557. [Google Scholar] [CrossRef] [PubMed]
- Saleem, H.; Zaidi, S.J. Nanoparticles in reverse osmosis membranes for desalination: A state of the art review. Desalination 2020, 475, 114171. [Google Scholar] [CrossRef]
- Yang, Z.; Sun, P.F.; Li, X.; Gan, B.; Wang, L.; Song, X.; Park, H.D.; Tang, C.Y. A critical review on thin-film nanocomposite membranes with interlayered structure: Mechanisms, recent developments, and environmental applications. Environ. Sci. Technol. 2020, 54, 15563–15583. [Google Scholar] [CrossRef] [PubMed]
- Song, X.; Gan, B.; Qi, S.; Guo, H.; Tang, C.Y.; Zhou, Y.; Gao, C. Intrinsic Nanoscale Structure of Thin Film Composite Polyamide Membranes: Connectivity, Defects, and Structure–Property Correlation. Environ. Sci. Technol. 2020, 54, 3559–3569. [Google Scholar] [CrossRef]
- Flemming, H.-C. Biofouling and me: My Stockholm syndrome with biofilms. Water Res. 2020, 173, 115576. [Google Scholar] [CrossRef]
- Bar-Zeev, E.; Passow, U.; Castrillón, S.R.-V.; Elimelech, M. Transparent Exopolymer Particles: From Aquatic Environments and Engineered Systems to Membrane Biofouling. Environ. Sci. Technol. 2014, 49, 691–707. [Google Scholar] [CrossRef]
- Horseman, T.; Yin, Y.; Christie, K.S.; Wang, Z.; Tong, T.; Lin, S. Wetting, Scaling, and Fouling in Membrane Distillation: State-of-the-Art Insights on Fundamental Mechanisms and Mitigation Strategies. ACS ES T Eng. 2021, 1, 117–140. [Google Scholar]
- Li, X.; Cao, Y.; Yu, H.; Kang, G.; Jie, X.; Liu, Z.; Yuan, Q. A novel composite nanofiltration membrane prepared with PHGH and TMC by interfacial polymerization. J. Membr. Sci. 2014, 466, 82–91. [Google Scholar] [CrossRef]
- Ansari, A.; Peña-Bahamonde, J.; Fanourakis, S.K.; Hu, Y.; Rodrigues, D.F. Microbially-induced mineral scaling in desalination conditions: Mechanisms and effects of commercial antiscalants. Water Res. 2020, 179, 115863. [Google Scholar] [CrossRef]
- Kochkodan, V.; Hilal, N. A comprehensive review on surface modified polymer membranes for biofouling mitigation. Desalination 2015, 356, 187–207. [Google Scholar] [CrossRef]
- Zheng, L.; Yu, D.; Wang, G.; Yue, Z.; Zhang, C.; Wang, Y.; Zhang, J.; Wang, J.; Liang, G.; Wei, Y. Characteristics and formation mechanism of membrane fouling in a full-scale RO wastewater reclamation process: Membrane autopsy and fouling characterization. J. Membr. Sci. 2018, 563, 843–856. [Google Scholar] [CrossRef]
- Jiang, S.-X.; Li, Y.-N.; Ladewig, B.P. A review of reverse osmosis membrane fouling and control strategies. Sci. Total Environ. 2017, 595, 567–583. [Google Scholar] [CrossRef]
- Zhang, X.; Huang, H.; Li, X.; Wang, J.; Wei, Y.; Zhang, H. Bioinspired chlorine-resistant tailoring for polyamide reverse osmosis membrane based on tandem oxidation of natural α-lipoic acid on the surface. J. Membr. Sci. 2021, 618, 118521. [Google Scholar] [CrossRef]
- Tang, C.Y.; Chong, T.H.; Fane, A.G. Colloidal interactions and fouling of NF and RO membranes: A review. Adv. Colloid Interface Sci. 2011, 164, 126–143. [Google Scholar] [CrossRef] [PubMed]
- Jeong, S.; Naidu, G.; Vollprecht, R.; Leiknes, T.; Vigneswaran, S. In-depth analyses of organic matters in a full-scale seawater desalination plant and an autopsy of reverse osmosis membrane. Sep. Purif. Technol. 2016, 162, 171–179. [Google Scholar] [CrossRef]
- Yang, Y.; Li, C.; Hou, L.-A. Impact of dead cells on biofouling and pharmaceutically active compounds retention by NF/RO membranes. Chem. Eng. J. 2018, 337, 51–59. [Google Scholar] [CrossRef]
- Zhang, W.-H.; Yin, M.-J.; Zhao, Q.; Jin, C.-G.; Wang, N.; Ji, S.; Ritt, C.L.; Elimelech, M.; An, Q.-F. Graphene oxide membranes with stable porous structure for ultrafast water transport. Nat. Nanotechnol. 2021, 16, 337–343. [Google Scholar] [CrossRef] [PubMed]
- Mu, S.; Wang, S.; Liang, S.; Xiao, K.; Fan, H.; Han, B.; Liu, C.; Wang, X.; Huang, X. Effect of the relative degree of foulant “hydrophobicity” on membrane fouling. J. Membr. Sci. 2019, 570–571, 1–8. [Google Scholar] [CrossRef]
- Bagheri, M.; Mirbagheri, S.A. Critical review of fouling mitigation strategies in membrane bioreactors treating water and wastewater. Bioresour. Technol. 2018, 258, 318–334. [Google Scholar] [CrossRef] [PubMed]
- Yin, Z.; Yang, C.; Long, C.; Li, A. Effect of integrated pretreatment technologies on RO membrane fouling for treating textile secondary effluent: Laboratory and pilot-scale experiments. Chem. Eng. J. 2018, 332, 109–117. [Google Scholar] [CrossRef]
- Yan, T.; Ye, Y.; Ma, H.; Zhang, Y.; Guo, W.; Du, B.; Wei, Q.; Wei, D.; Ngo, H.H. A critical review on membrane hybrid system for nutrient recovery from wastewater. Chem. Eng. J. 2018, 348, 143–156. [Google Scholar] [CrossRef]
- Zhao, X.; Zhang, R.; Liu, Y.; He, M.; Su, Y.; Gao, C.; Jiang, Z. Antifouling membrane surface construction: Chemistry plays a critical role. J. Membr. Sci. 2018, 551, 145–171. [Google Scholar] [CrossRef]
- Wang, Y.H.; Wu, Y.H.; Tong, X.; Yu, T.; Peng, L.; Bai, Y.; Zhao, X.H.; Huo, Z.Y.; Ikuno, N.; Hu, H.Y. Chlorine disinfection significantly aggravated the biofouling of reverse osmosis membrane used for municipal wastewater reclamation. Water Res. 2019, 154, 246–257. [Google Scholar] [CrossRef] [PubMed]
- Huang, S.; Voutchkov, N.; Jiang, S. Balancing carbon, nitrogen and phosphorus concentration in seawater as a strategy to prevent accelerated membrane biofouling. Water Res. 2019, 165, 114978. [Google Scholar] [CrossRef]
- Otitoju, T.A.; Saari, R.A.; Ahmad, A.L. Progress in the modification of reverse osmosis (RO) membranes for enhanced performance. J. Ind. Eng. Chem. 2018, 67, 52–71. [Google Scholar] [CrossRef]
- Zhao, J.; Zhao, X.; Jiang, Z.; Li, Z.; Fan, X.; Zhu, J.; Wu, H.; Su, Y.; Yang, D.; Pan, F.; et al. Biomimetic and bioinspired membranes: Preparation and application. Prog. Polym. Sci. 2014, 39, 1668–1720. [Google Scholar] [CrossRef]
- Ayyavoo, J.; Nguyen, T.P.N.; Jun, B.-M.; Kim, I.-C.; Kwon, Y.-N. Protection of polymeric membranes with antifouling surfacing via surface modifications. Colloids Surf. A Physicochem. Eng. Asp. 2016, 506, 190–201. [Google Scholar] [CrossRef]
- Kang, G.-D.; Cao, Y.-M. Development of antifouling reverse osmosis membranes for water treatment: A review. Water Res. 2012, 46, 584–600. [Google Scholar] [CrossRef]
- Sheng, G.-P.; Yu, H.-Q.; Li, X.-Y. Extracellular polymeric substances (EPS) of microbial aggregates in biological wastewater treatment systems: A review. Biotechnol. Adv. 2010, 28, 882–894. [Google Scholar] [CrossRef]
- Abushaban, A.; Salinas-Rodriguez, S.-G.; Philibert, M.; Bouille, L.-L.; Necibi, M.C.; Chehbouni, A. Biofouling potential indicators to assess pretreatment and mitigate biofouling in SWRO membranes: A short review. Desalination 2022, 527, 115543. [Google Scholar] [CrossRef]
- Cai, T.; Li, X.; Wan, C.; Chung, T.-S. Zwitterionic polymers grafted poly(ether sulfone) hollow fiber membranes and their antifouling behaviors for osmotic power generation. J. Membr. Sci. 2016, 497, 142–152. [Google Scholar] [CrossRef]
- Yimyai, T.; Thiramanas, R.; Phakkeeree, T.; Iamsaard, S.; Crespy, D. Adaptive Coatings with Anticorrosion and Antibiofouling Properties. Adv. Funct. Mater. 2021, 31, 2102568. [Google Scholar] [CrossRef]
- Nava-Ocampo, M.F.; Bucs, S.S.; Farinha, A.S.; Son, M.; Logan, B.E.; Vrouwenvelder, J.S. Sacrificial coating development for biofouling control in membrane systems. Desalination 2020, 496, 114650. [Google Scholar] [CrossRef]
- Ben-Sasson, M.; Lu, X.; Nejati, S.; Jaramillo, H.; Elimelech, M. In situ surface functionalization of reverse osmosis membranes with biocidal copper nanoparticles. Desalination 2016, 388, 1–8. [Google Scholar] [CrossRef] [Green Version]
- Ben-Sasson, M.; Lu, X.; Bar-Zeev, E.; Zodrow, K.R.; Nejati, S.; Qi, G.; Giannelis, E.P.; Elimelech, M. In situ formation of silver nanoparticles on thin-film composite reverse osmosis membranes for biofouling mitigation. Water Res. 2014, 62, 260–270. [Google Scholar] [CrossRef] [PubMed]
- Nikkola, J.; Liu, X.; Li, Y.; Raulio, M.; Alakomi, H.-L.; Wei, J.; Tang, C.Y. Surface modification of thin film composite RO membrane for enhanced anti-biofouling performance. J. Membr. Sci. 2013, 444, 192–200. [Google Scholar] [CrossRef]
- Liu, C.; Liu, Y.; Guo, Y.; Wang, C.; Hu, Z.; Zhang, C. High-hydrophilic and salt rejecting PA-g/co-PVP RO membrane via bionic sand-fixing grass for pharmaceutical wastewater treatment. Chem. Eng. J. 2019, 357, 269–279. [Google Scholar] [CrossRef]
- Li, S.-L.; Wu, P.; Wang, J.; Wang, J.; Hu, Y. Fabrication of high performance polyamide reverse osmosis membrane from monomer 4-morpholino-m-phenylenediamine and tailoring with zwitterions. Desalination 2020, 473, 114169. [Google Scholar] [CrossRef]
- Cruz-Silva, R.; Takizawa, Y.; Nakaruk, A.; Katouda, M.; Yamanaka, A.; Ortiz-Medina, J.; Morelos-Gomez, A.; Tejima, S.; Obata, M.; Takeuchi, K.; et al. New Insights in the Natural Organic Matter Fouling Mechanism of Polyamide and Nanocomposite Multiwalled Carbon Nanotubes-Polyamide Membranes. Environ. Sci. Technol. 2019, 53, 6255–6263. [Google Scholar] [CrossRef] [PubMed]
- Liu, C.; Guo, Y.; Zhang, J.; Tian, B.; Lin, O.; Liu, Y.; Zhang, C. Tailor-made high-performance reverse osmosis membranes by surface fixation of hydrophilic macromolecules for wastewater treatment. RSC Adv. 2019, 9, 17766–17777. [Google Scholar] [CrossRef] [Green Version]
- Miao, A.; Wei, M.; Xu, F.; Wang, Y. Influence of membrane hydrophilicity on water permeability: An experimental study bridging simulations. J. Membr. Sci. 2020, 604, 118087. [Google Scholar] [CrossRef]
- De Oliveira, F.F.; Schneider, R.P. Slow sand filtration for biofouling reduction in seawater desalination by reverse osmosis. Water Res. 2019, 155, 474–486. [Google Scholar] [CrossRef] [PubMed]
- Banerjee, I.; Pangule, R.C.; Kane, R.S. Antifouling Coatings: Recent Developments in the Design of Surfaces That Prevent Fouling by Proteins, Bacteria, and Marine Organisms. Adv. Mater. 2011, 23, 690–718. [Google Scholar] [CrossRef] [PubMed]
- Xia, J.; Gu, J.; Xiao, P.; Zhang, C.; Yan, L.; Chen, T. Supramolecular fabrication of hyperbranched polyethyleneimine toward nanofiltration membrane for efficient wastewater purification. SusMat 2021, 1, 558–568. [Google Scholar] [CrossRef]
- Jiang, J.; Zhu, L.; Zhu, L.; Zhang, H.; Zhu, B.; Xu, Y. Antifouling and Antimicrobial Polymer Membranes Based on Bioinspired Polydopamine and Strong Hydrogen-Bonded Poly(N-vinyl pyrrolidone). ACS Appl. Mater. Interfaces 2013, 5, 12895–12904. [Google Scholar] [CrossRef]
- Cheng, W.; Lu, X.; Kaneda, M.; Zhang, W.; Bernstein, R.; Ma, J.; Elimelech, M. Graphene Oxide-Functionalized Membranes: The Importance of Nanosheet Surface Exposure for Biofouling Resistance. Environ. Sci. Technol. 2020, 54, 517–526. [Google Scholar] [CrossRef]
- Jiang, B.-B.; Sun, X.-F.; Wang, L.; Wang, S.-Y.; Liu, R.-D.; Wang, S.-G. Polyethersulfone membranes modified with D-tyrosine for biofouling mitigation: Synergistic effect of surface hydrophility and anti-microbial properties. Chem. Eng. J. 2017, 311, 135–142. [Google Scholar] [CrossRef]
- Guo, X.; Fan, S.; Hu, Y.; Fu, X.; Shao, H.; Zhou, Q. A novel membrane biofouling mitigation strategy of D-amino acid supported by polydopamine and halloysite nanotube. J. Membr. Sci. 2019, 579, 131–140. [Google Scholar] [CrossRef]
- Park, S.-H.; Hwang, S.O.; Kim, T.-S.; Cho, A.; Kwon, S.J.; Kim, K.T.; Park, H.-D.; Lee, J.-H. Triclosan-immobilized polyamide thin film composite membranes with enhanced biofouling resistance. Appl. Surf. Sci. 2018, 443, 458–466. [Google Scholar] [CrossRef]
- El-Arnaouty, M.; Ghaffar, A.A.; Eid, M.; Aboulfotouh, M.E.; Taher, N.; Soliman, E.-S. Nano-modification of polyamide thin film composite reverse osmosis membranes by radiation grafting. J. Radiat. Res. Appl. Sci. 2018, 11, 204–216. [Google Scholar] [CrossRef] [Green Version]
- Ma, W.; Soroush, A.; Luong, T.V.A.; Rahaman, S. Cysteamine- and graphene oxide-mediated copper nanoparticle decoration on reverse osmosis membrane for enhanced anti-microbial performance. J. Colloid Interface Sci. 2017, 501, 330–340. [Google Scholar] [CrossRef]
- Khajouei, M.; Jahanshahi, M.; Peyravi, M. Biofouling mitigation of TFC membrane by in-situ grafting of PANI/Cu couple nanoparticle. J. Taiwan Inst. Chem. Eng. 2018, 85, 237–247. [Google Scholar] [CrossRef]
- Kang, G.; Yu, H.; Liu, Z.; Cao, Y. Surface modification of a commercial thin film composite polyamide reverse osmosis membrane by carbodiimide-induced grafting with poly(ethylene glycol) derivatives. Desalination 2011, 275, 252–259. [Google Scholar] [CrossRef]
- Nikolaeva, D.; Langner, C.; Ghanem, A.; Rehim, M.A.; Voit, B.; Meier-Haack, J. Hydrogel surface modification of reverse osmosis membranes. J. Membr. Sci. 2015, 476, 264–276. [Google Scholar] [CrossRef]
- Xu, J.; Wang, Z.; Wang, J.; Wang, S. Positively charged aromatic polyamide reverse osmosis membrane with high anti-fouling property prepared by polyethylenimine grafting. Desalination 2015, 365, 398–406. [Google Scholar] [CrossRef]
- Wang, A.; Fang, W.; Zhang, J.; Gao, S.; Zhu, Y.; Jin, J. Zwitterionic nanohydrogels-decorated microporous membrane with ultrasensitive salt responsiveness for controlled water transport. Small 2020, 16, e1903925. [Google Scholar] [CrossRef] [PubMed]
- Mahdavi, H.; Rahimi, A. Zwitterion functionalized graphene oxide/polyamide thin film nanocomposite membrane: Towards improved anti-fouling performance for reverse osmosis. Desalination 2018, 433, 94–107. [Google Scholar] [CrossRef]
- Yang, Z.; Saeki, D.; Matsuyama, H. Zwitterionic polymer modification of polyamide reverse-osmosis membranes via surface amination and atom transfer radical polymerization for anti-biofouling. J. Membr. Sci. 2018, 550, 332–339. [Google Scholar] [CrossRef]
- Wang, J.; Wang, Z.; Wang, J.; Wang, S. Improving the water flux and bio-fouling resistance of reverse osmosis (RO) membrane through surface modification by zwitterionic polymer. J. Membr. Sci. 2015, 493, 188–199. [Google Scholar] [CrossRef]
- Lan, Y.; Hiebner, D.W.; Casey, E. Self-assembly and regeneration strategy for mitigation of membrane biofouling by the exploitation of enzymatic nanoparticles. Chem. Eng. J. 2021, 412, 128666. [Google Scholar] [CrossRef]
- Jiang, S.; Sreethawong, T.; Lee, S.S.C.; Low, M.B.J.; Win, K.Y.; Brzozowska, A.M.; Teo, S.L.-M.; Vancso, G.J.; Jańczewski, D.; Han, M.-Y. Fabrication of copper nanowire films and their incorporation into polymer matrices for antibacterial and marine antifouling applications. Adv. Mater. Interfaces 2015, 2, 1400483. [Google Scholar] [CrossRef] [Green Version]
- Jeon, S.; Lee, J.-H. Rationally designed in-situ fabrication of thin film nanocomposite membranes with enhanced desalination and anti-biofouling performance. J. Membr. Sci. 2020, 615, 118542. [Google Scholar] [CrossRef]
- Yang, E.; Alayande, A.B.; Kim, C.-M.; Song, J.-H.; Kim, I.S. Laminar reduced graphene oxide membrane modified with silver nanoparticle-polydopamine for water/ion separation and biofouling resistance enhancement. Desalination 2018, 426, 21–31. [Google Scholar] [CrossRef]
- Aymonier, C.; Schlotterbeck, U.; Antonietti, L.; Zacharias, P.; Thomann, R.; Tiller, J.C.; Mecking, S. Hybrids of silver nanoparticles with amphiphilic hyperbranched macromolecules exhibiting antimicrobial properties. Chem. Commun. 2002, 24, 3018–3019. [Google Scholar] [CrossRef] [Green Version]
- Zodrow, K.; Brunet, L.; Mahendra, S.; Li, D.; Zhang, A.; Li, Q.; Alvarez, P.J. Polysulfone ultrafiltration membranes impregnated with silver nanoparticles show improved biofouling resistance and virus removal. Water Res. 2009, 43, 715–723. [Google Scholar] [CrossRef] [Green Version]
- Liu, Z.; Hu, Y. Sustainable Antibiofouling Properties of Thin Film Composite Forward Osmosis Membrane with Rechargeable Silver Nanoparticles Loading. ACS Appl. Mater. Interfaces 2016, 8, 21666–21673. [Google Scholar] [CrossRef]
- Pi, J.-K.; Yang, H.-C.; Wan, L.-S.; Wu, J.; Xu, Z.-K. Polypropylene microfiltration membranes modified with TiO2 nanoparticles for surface wettability and antifouling property. J. Membr. Sci. 2016, 500, 8–15. [Google Scholar] [CrossRef]
- Adán, C.; Marugán, J.; Mesones, S.; Casado, C.; van Grieken, R. Bacterial inactivation and degradation of organic molecules by titanium dioxide supported on porous stainless steel photocatalytic membranes. Chem. Eng. J. 2017, 318, 29–38. [Google Scholar] [CrossRef]
- Katz, A.; McDonagh, A.; Tijing, L.; Shon, H.K. Fouling and inactivation of titanium dioxide-based photocatalytic systems. Crit. Rev. Environ. Sci. Technol. 2015, 45, 1880–1915. [Google Scholar] [CrossRef] [Green Version]
- Zhang, Y.; Wang, Z.; Lin, W.; Sun, H.; Wu, L.; Chen, S. A facile method for polyamide membrane modification by poly(sulfobetaine methacrylate) to improve fouling resistance. J. Membr. Sci. 2013, 446, 164–170. [Google Scholar] [CrossRef]
- Saeki, D.; Tanimoto, T.; Matsuyama, H. Prevention of bacterial adhesion on polyamide reverse osmosis membranes via electrostatic interactions using a cationic phosphorylcholine polymer coating. Colloids Surf. A Physicochem. Eng. Asp. 2014, 443, 171–176. [Google Scholar] [CrossRef]
- Fei, P.; Liao, L.; Meng, J.; Cheng, B.; Hu, X.; Song, J. Non-leaching antibacterial cellulose triacetate reverse osmosis membrane via covalent immobilization of quaternary ammonium cations. Carbohydr. Polym. 2018, 181, 1102–1111. [Google Scholar] [CrossRef]
- Xu, C.; Jiang, J.; Oguzlu, H.; Zheng, Y.; Jiang, F. Antifouling, antibacterial and non-cytotoxic transparent cellulose membrane with grafted zwitterion and quaternary ammonium copolymers. Carbohydr. Polym. 2020, 250, 116960. [Google Scholar] [CrossRef]
- Zhao, H.-Z.; Wang, L.; Chang, Y.-Y.; Xu, Y. High-efficiency removal of perfluorooctanoic acid from water by covalently bound hybrid coagulants (CBHyC) bearing a hydrophobic quaternary ammonium group. Sep. Purif. Technol. 2016, 158, 9–15. [Google Scholar] [CrossRef]
- Li, W.; Wang, S.; Zhang, X.; Wang, W.; Xie, X.; Pei, P. Degradation of guanidinium-functionalized anion exchange membrane during alkaline environment. Int. J. Hydrogen Energy 2014, 39, 13710–13717. [Google Scholar] [CrossRef]
- Yang, H.; Guo, X.; Chen, R.; Liu, Q.; Liu, J.; Yu, J.; Lin, C.; Wang, J.; Zhang, M. A hybrid sponge with guanidine and phytic acid enriched surface for integration of antibiofouling and uranium uptake from seawater. Appl. Surf. Sci. 2020, 525, 146611. [Google Scholar] [CrossRef]
- Liao, Y.; Wang, M.; Chen, D. Electrosorption of uranium(VI) by highly porous phosphate-functionalized graphene hydrogel. Appl. Surf. Sci. 2019, 484, 83–96. [Google Scholar] [CrossRef]
- Nelson, J.; Atilho, R.; Sherlock, M.; Stockbridge, R.; Breaker, R.R. Metabolism of Free Guanidine in Bacteria Is Regulated by a Widespread Riboswitch Class. Mol. Cell 2017, 65, 220–230. [Google Scholar] [CrossRef] [PubMed] [Green Version]
- Li, Z.; Yu, Z.; Wu, Y.; Wu, X.; Wan, Y.; Yuan, Y.; Wang, N. Self-sterilizing diblock polycation-enhanced polyamidoxime shape-stable blow-spun nanofibers for high-performance uranium capture from seawater. Chem. Eng. J. 2020, 390, 124648. [Google Scholar] [CrossRef]
- He, N.; Li, H.; Li, L.; Cheng, C.; Lu, X.; Wen, J.; Wang, X. Polyguanidine-modified adsorbent to enhance marine applicability for uranium recovery from seawater. J. Hazard Mater. 2021, 416, 126192. [Google Scholar] [CrossRef] [PubMed]
- Zhao, D.; Yu, S. A review of recent advance in fouling mitigation of NF/RO membranes in water treatment: Pretreatment, membrane modification, and chemical cleaning. Desalination Water Treat. 2014, 55, 870–891. [Google Scholar] [CrossRef]
- Zhang, H.-L.; Gao, Y.-B.; Gai, J.-G. Guanidinium-functionalized nanofiltration membranes integrating anti-fouling and antimicrobial effects. J. Mater. Chem. A 2018, 6, 6442–6454. [Google Scholar] [CrossRef]
- Zhang, H.-L.; Hua, L.-B.; Yang, M.-B.; Gai, J.-G. Sulfaguanidine nanofiltration active layer towards anti-adhesive and antimicrobial attributes for desalination and dye removal. RSC Adv. 2019, 9, 20715–20727. [Google Scholar] [CrossRef] [Green Version]
- Demir, B.; Cerkez, I.; Worley, S.D.; Broughton, R.M.; Huang, T.-S. N-Halamine-Modified Antimicrobial Polypropylene Nonwoven Fabrics for Use against Airborne Bacteria. ACS Appl. Mater. Interfaces 2014, 7, 1752–1757. [Google Scholar] [CrossRef]
- Xu, X.; Wang, Y.; Zhang, D.; Wang, J.; Yang, Z. In situ growth of photocatalytic Ag-decorated β-Bi2O3/Bi2O2.7 heterostructure film on PVC polymer matrices with self-cleaning and antibacterial properties. Chem. Eng. J. 2021, 429, 131058. [Google Scholar] [CrossRef]
- Prince, J.; Bhuvana, S.; Boodhoo, K.; Anbharasi, V.; Singh, G. Synthesis and characterization of PEG-Ag immobilized PES hollow fiber ultrafiltration membranes with long lasting antifouling properties. J. Membr. Sci. 2014, 454, 538–548. [Google Scholar] [CrossRef] [Green Version]
- Wang, Y.; Wang, Z.; Han, X.; Wang, J.; Wang, S. Improved flux and anti-biofouling performances of reverse osmosis membrane via surface layer-by-layer assembly. J. Membr. Sci. 2017, 539, 403–411. [Google Scholar] [CrossRef]
- Wang, Y.; Wang, Z.; Wang, J.-X.; Wang, S.-C. Triple antifouling strategies for reverse osmosis membrane biofouling control. J. Membr. Sci. 2018, 549, 495–506. [Google Scholar] [CrossRef]
- Li, S.; Zhao, S.; Pei, J.; Wang, H.; Meng, H.; Vrouwenvelder, J.S.; Li, Z. Stimuli-Responsive Lysozyme Nanocapsule Engineered Microfiltration Membranes with a Dual-Function of Anti-Adhesion and Antibacteria for Biofouling Mitigation. ACS Appl. Mater. Interfaces 2021, 13, 32205–32216. [Google Scholar] [CrossRef]
- Wu, X.; Luo, N.; Xie, S.; Zhang, H.; Zhang, Q.; Wang, F.; Wang, Y. Photocatalytic transformations of lignocellulosic biomass into chemicals. Chem. Soc. Rev. 2020, 49, 6198–6223. [Google Scholar] [CrossRef]
- Kong, X.; Liu, X.; Zheng, Y.; Chu, P.K.; Zhang, Y.; Wu, S. Graphitic carbon nitride-based materials for photocatalytic antibacterial application. Mater. Sci. Eng. R Rep. 2021, 145, 100610. [Google Scholar] [CrossRef]
- Ji, L.; Yan, L.; Chao, M.; Li, M.; Gu, J.; Lei, M.; Zhang, Y.; Wang, X.; Xia, J.; Chen, T.; et al. Sphagnum Inspired g-C 3 N 4 Nano/Microspheres with Smaller Bandgap in Heterojunction Membranes for Sunlight-Driven Water Purification. Small 2021, 17, 2007122. [Google Scholar] [CrossRef]
- Cui, W.; Li, F.; Xu, R.; Zhang, C.; Chen, X.; Yan, R.; Liang, R.; Qiu, J. Regenerable Covalent Organic Frameworks for Photo-enhanced Uranium Adsorption from Seawater. Angew. Chem. Int. Ed. 2020, 59, 17684–17690. [Google Scholar] [CrossRef]
- Ni, L.; Zhu, Y.; Ma, J.; Wang, Y. Novel strategy for membrane biofouling control in MBR with CdS/MIL-101 modified PVDF membrane by in situ visible light irradiation. Water Res. 2021, 188, 116554. [Google Scholar] [CrossRef] [PubMed]
- Jeong, E.; Byun, J.; Bayarkhuu, B.; Hong, S.W. Hydrophilic photocatalytic membrane via grafting conjugated polyelectrolyte for visible-light-driven biofouling control. Appl. Catal. B Environ. 2021, 282, 119587. [Google Scholar] [CrossRef]
- Ni, L.; Wang, T.; Wang, H.; Wang, Y. An anaerobic-applicable Bi2MoO6/CuS heterojunction modified photocatalytic membrane for biofouling control in anammox MBRs: Generation and contribution of reactive species. Chem. Eng. J. 2022, 429, 132457. [Google Scholar] [CrossRef]
- Yan, L.-K.; Zhang, G.; Zhang, L.; Zhang, W.; Gu, J.-C.; Huang, Y.-J.; Zhang, J.-W.; Chen, T. Robust construction of underwater superoleophobic CNTs/nanoparticles multifunctional hybrid membranes via interception effect for oily wastewater purification. J. Membr. Sci. 2019, 569, 32–40. [Google Scholar] [CrossRef]
- Yan, L.; Liu, C.; Xia, J.; Chao, M.; Wang, W.; Gu, J.; Chen, T. CNTs/TiO2 composite membrane with adaptable wettability for on-demand oil/water separation. J. Clean. Prod. 2020, 275, 124011. [Google Scholar] [CrossRef]

Publisher’s Note: MDPI stays neutral with regard to jurisdictional claims in published maps and institutional affiliations. |
© 2022 by the authors. Licensee MDPI, Basel, Switzerland. This article is an open access article distributed under the terms and conditions of the Creative Commons Attribution (CC BY) license (https://creativecommons.org/licenses/by/4.0/).
Share and Cite
Zhang, H.; Zhu, S.; Yang, J.; Ma, A. Advancing Strategies of Biofouling Control in Water-Treated Polymeric Membranes. Polymers 2022, 14, 1167. https://doi.org/10.3390/polym14061167
Zhang H, Zhu S, Yang J, Ma A. Advancing Strategies of Biofouling Control in Water-Treated Polymeric Membranes. Polymers. 2022; 14(6):1167. https://doi.org/10.3390/polym14061167
Chicago/Turabian StyleZhang, Hongli, Shilin Zhu, Jie Yang, and Aijie Ma. 2022. "Advancing Strategies of Biofouling Control in Water-Treated Polymeric Membranes" Polymers 14, no. 6: 1167. https://doi.org/10.3390/polym14061167
APA StyleZhang, H., Zhu, S., Yang, J., & Ma, A. (2022). Advancing Strategies of Biofouling Control in Water-Treated Polymeric Membranes. Polymers, 14(6), 1167. https://doi.org/10.3390/polym14061167

